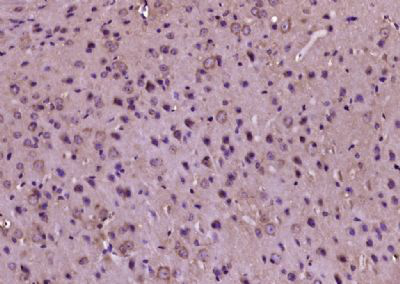
产品细节图片1

相关产品推荐更多 >
万千商家帮你免费找货
0 人在求购买到急需产品
- 详细信息
- 文献和实验
- 技术资料
- 供应商:
江西江蓝纯生物试剂有限公司
- 库存:
185
- 克隆性:
单克隆
- 保质期:
1年
- 抗体英文名:
Phospho-PERK (Thr980)
- 抗体名:
磷酸化蛋白激酶样内质网激酶抗体
- 适应物种:
人/动物/植物
- 应用范围:
WB,ELISA等
- 浓度:
1mg/ml
- 保存条件:
-20 °
- 规格:
100ul
英文名称 : Phospho-PERK (Thr980)
中文名称 : 磷酸化蛋白激酶样内质网激酶抗体
别 名 : p-PERK(Thr980); PERK(Phospho Thr980); PERK(Phospho T980); Phospho-PERK(Thr982)(human); HRI; HsPEK; Pancreatic eIF2-alpha kinase; PEK; PRKR like endoplasmic reticulum kinase; WRS; DKFZp781H1925; EC 2.7.11.1; EIF2AK3; Eukaryotic translation initiation factor 2 alpha kinase 3; Heme regulated EIF2 alpha kinase.
产品类型 : 磷酸化抗体
研究领域 : 肿瘤 细胞生物 免疫学 信号转导 细胞凋亡 转录调节因子 激酶和磷酸酶
抗体来源 : Rabbit
克隆类型 : Polyclonal
交叉反应 : Human, Mouse, Rat, Rabbit,
产品应用 : ELISA=1:500-1000 IHC-P=1:400-800 IHC-F=1:400-800 ICC=1:100-500 IF=1:100-500 (石蜡切片需做抗原修复)
not yet tested in other applications.
optimal dilutions/concentrations should be determined by the end user.
分 子 量 : 119kDa
细胞定位 : 细胞浆 细胞膜
性 状 : Lyophilized or Liquid
浓 度 : 1mg/ml
免 疫 原 : KLH conjugated synthesised phosphopeptide derived from human PERK around the phosphorylation site of Thr980:H(p-T)GQ
亚 型 : IgG
纯化方法 : affinity purified by Protein A
储 存 液 : 0.01M TBS(pH7.4) with 1% BSA, 0.03% Proclin300 and 50% Glycerol.
保存条件 : Store at -20 °C for one year. Avoid repeated freeze/thaw cycles. The lyophilized antibody is stable at room temperature for at least one month and for greater than a year when kept at -20°C. When reconstituted in sterile pH 7.4 0.01M PBS or diluent of antibody the antibody is stable for at least two weeks at 2-4 °C.
PubMed : PubMed
产品介绍 : The protein encoded by this gene phosphorylates the alpha subunit of eukaryotic translation-initiation factor 2 (EIF2), leading to its inactivation, and thus to a rapid reduction of translational initiation and repression of global protein synthesis. It is a type I membrane protein located in the endoplasmic reticulum (ER), where it is induced by ER stress caused by malfolded proteins. Mutations in this gene are associated with Wolcott-Rallison syndrome. [provided by RefSeq, Jan 2010].
Function:
Phosphorylates the alpha subunit of eukaryotic translation-initiation factor 2 (EIF2), leading to its inactivation and thus to a rapid reduction of translational initiation and repression of global protein synthesis. Serves as a critical effector of unfolded protein response (UPR)-induced G1 growth arrest due to the loss of cyclin D1.
Subunit:
Forms dimers with HSPA5/BIP in resting cells. Oligomerizes in ER-stressed cells. Interacts with DNAJC3.
Subcellular Location:
Endoplasmic reticulum membrane; Single-pass type I membrane protein.
Tissue Specificity:
Ubiquitous.
Post-translational modifications:
Autophosphorylated.
N-glycosylated.
Similarity:
Belongs to the protein kinase superfamily. Ser/Thr protein kinase family. GCN2 subfamily.
Contains 1 protein kinase domain.
SWISS:
Q9Z2B5
Gene ID:
13666
Important Note:
This product as supplied is intended for research use only, not for use in human, therapeutic or diagnostic applications.
产品图片
风险提示:丁香通仅作为第三方平台,为商家信息发布提供平台空间。用户咨询产品时请注意保护个人信息及财产安全,合理判断,谨慎选购商品,商家和用户对交易行为负责。对于医疗器械类产品,请先查证核实企业经营资质和医疗器械产品注册证情况。
 文献和实验
文献和实验大鼠磷酸化蛋白激酶C (P-PKC )酶联免疫分析 试剂盒使用说明书 本试剂仅供研究使用 目的:本试剂盒用于测定大鼠血清,血浆,细胞上清及相关液体样本中磷酸化蛋白激酶C (P-PKC )的含量。 实验原理: 本试剂盒应用双抗体夹心法测定标本中大鼠磷酸化蛋白激酶 C ( P-PKC )水平。用纯化的大鼠磷酸化蛋白激酶 C ( P-PKC )抗体包被微孔板,制成固相抗体,往包被单抗的微孔中依次加入磷酸化蛋白激酶
人磷酸化蛋白激酶C(phos-PKC)ELISA试剂盒 说明书
上海西唐生物科技有限公司 021-55229872, 65333639 www.westang.com 人磷酸化蛋白激酶C (phos-PKC)ELISA 试剂盒 ( 用于血清、血浆、细胞培养上清液和其它生物体液内 ) 原理 本实验采用双抗体夹心 ABC-ELISA 法。用抗人 phos-PKC 单抗包被于酶标板上,标准品和样品中的 phos-PKC与单抗结合,加入生物
Cell Metab:浙大吕志民团队揭示肿瘤细胞 Warburg 效应促进肿瘤免疫逃逸
2 从线粒体外膜脱落,进入细胞浆中。在细胞浆中,HK2 结合 NF-κB 的抑制因子 IκBα。 重要的是,HK2 发挥了不依赖于其经典代谢功能的新功能,即作为一个蛋白激酶磷酸化 IκBα 的 Thr 291 位点。该磷酸化促进了蛋白酶 μ-calpain 与 IκBα 的结合并进一步降解 IκBα,进而使转录因子 NF-κB 入核,最终促进了 PD-L1 的表达并导致了肿瘤的免疫逃逸。作者还发现,使用己糖激酶的抑制剂与 PD-1 抗体联用治疗小鼠胶质瘤,可以显著提升 PD-1 抗体的治疗











